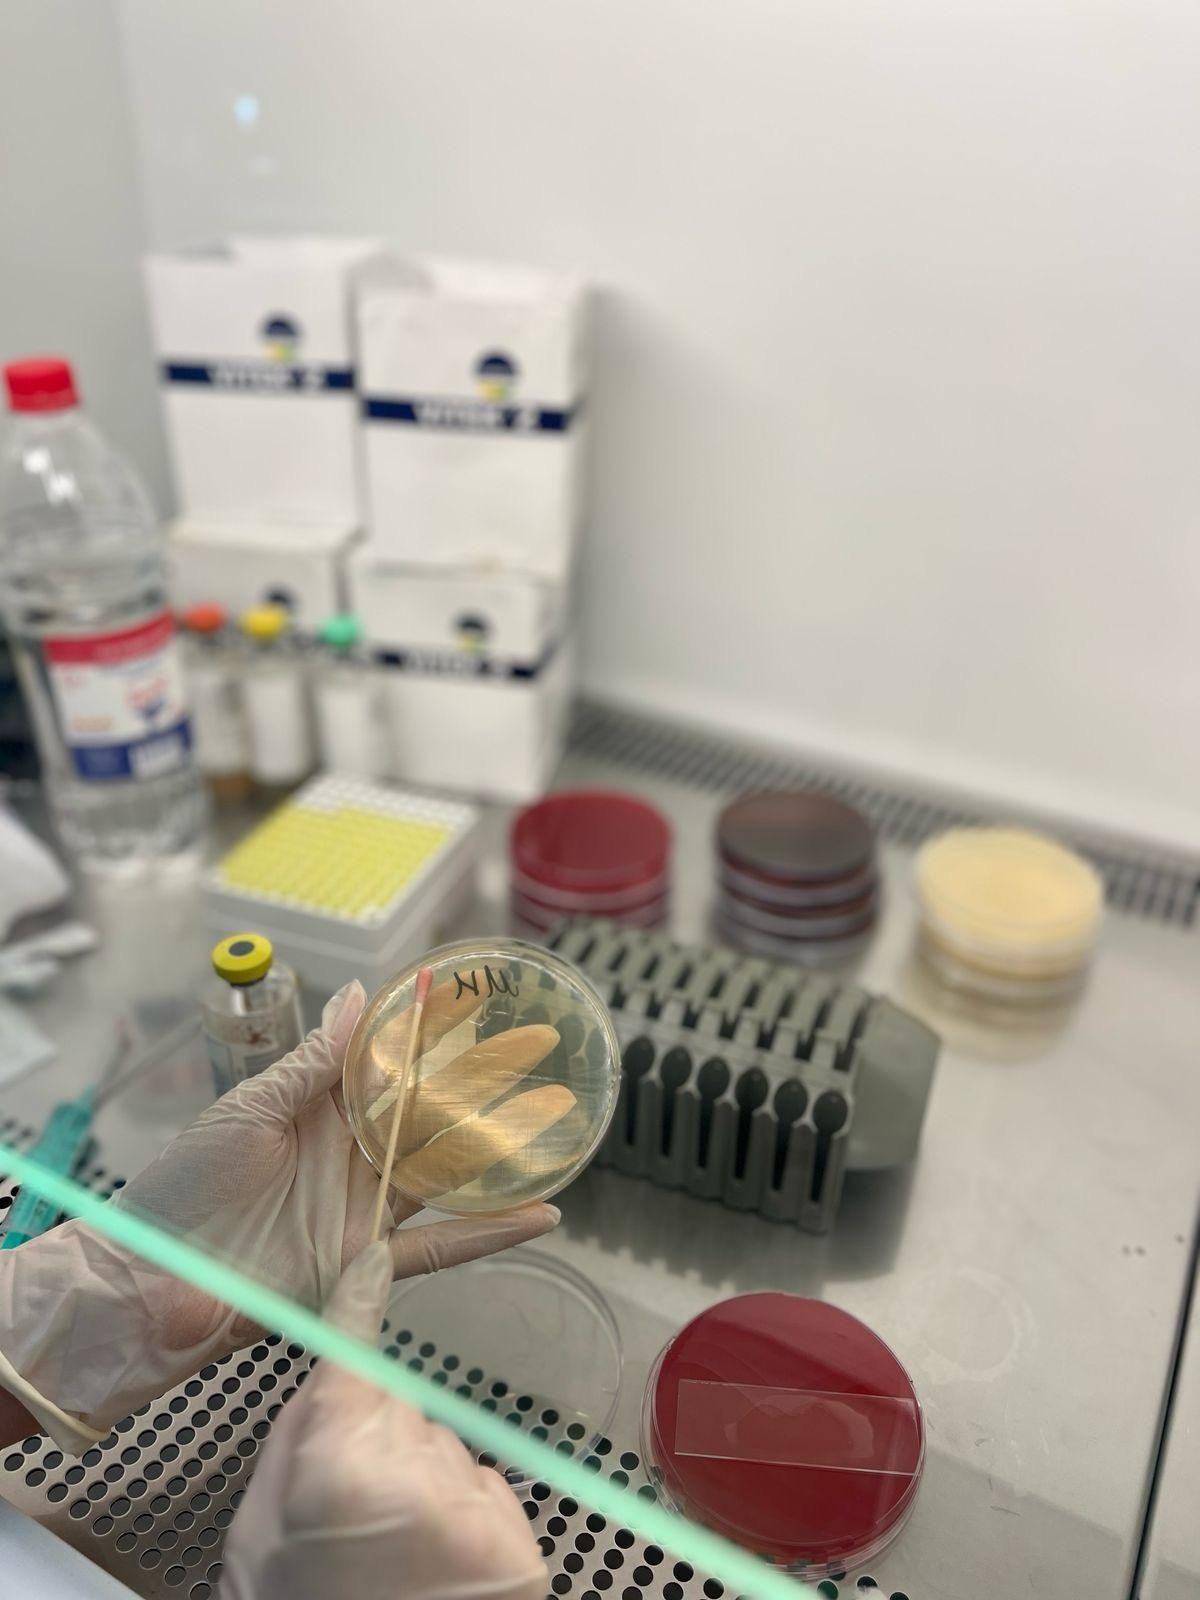

- Ana səhifə
-
UNİVERSİTET
UNİVERSİTET
- Təhsil
-
ELM VƏ ARAŞDIRMA
ELM VƏ ARAŞDIRMA
- FAKÜLTƏLƏR
Heydər Əliyev



ATU-nun Tədris Cərrahiyyə Klinikasının Klinik-Diaqnostik Laboratoriyası ən müasir avadanlıqlarla təchiz olunub
Azərbaycan Tibb Universitetinin Tədris Cərrahiyyə Klinikasının Klinik-Diaqnostik Laboratoriyası 2014-cü ildən etibarən fəaliyyət göstərməkdədir. Laboratoriya müasir, tam avtomatlaşdırılmış avadanlıqlarla təchiz olunub və burada biokimyəvi, mikrobioloji, immunoloji, hematoloji, molekulyar və mikroskopik bölmələr üzrə 800-ə yaxın laborator müayinə aparılır.
Xidmət sahələri ilə bağlı ətraflı məlumat əldə etmək məqsədilə şöbə müdiri Leyla Həşimova ilə görüşdük: “İlk öncə bildirmək istərdim ki, 2025-ci ilin yanvar ayından etibarən Tədris Cərrahiyyə Klinikası İcbari Tibbi Sığorta sisteminə daxil edilib və burada sığorta çərçivəsində tibbi xidmətlər göstərilməyə başlanıb. Qeyd edim ki, İcbari Tibbi Sığortanın Xidmətlər Zərfinə daxil olan cərrahi tibbi xidmətlər çərçivəsində əməliyyatdan əvvəl tələb olunan laborator müayinələr İTS tərəfindən qarşılanır.
O ki qaldı bölmələrimizə, mikrobioloji bölmədə bütün patoloji nümunələrdə (abses, yara, steril bədən mayeləri, bəlğəm, əməliyyat materialı və s.) bakteriya (göbələk) kulturası və izolə olunan patogenə uyğun antibiotik həssaslıq testi aparılır. Nümunələrin dəyərləndirilməsi Klinik Mikrobiyoloji Uzmanlık Dərnəyi (KLİMUD) rəhbərlərinə, antibiotik həssaslıq testləri isə Avropa Klinik Mikrobiologiya və Yoluxucu Xəstəliklər Cəmiyyətinin (EUCAST) standartlarına uyğun olaraq həyata keçirilir. EUCAST standartları hər ilin yanvar ayında yenilənir və laboratoriya da bu yeniliklərə uyğun fəaliyyətini təşkil edir. Laboratoriyamız beynəlxalq standartlara cavab verən tam avtomatlaşdırılmış identifikasiya və antibiotik həssaslıq cihazları ilə təchiz olunub”.
Şöbə müdiri qeyd edib ki, avtomat sistem nəticələrinin ənənəvi üsullardan üstünlüyü ondan ibarətdir ki, antibiotikə həssaslıq testinin nəticələrini Minimal İnhibisiya Konsentrasiyası (MİK) dəyəri ilə verir. Bu da bakteremiyası olan xəstələr üçün kritik əhəmiyyət kəsb edir. Laboratoriyamızda pozitiv qan kulturasından sürətli antibiotik həssaslıq testi tətbiq olunur. Xüsusilə yenidoğulmuşların qan nümunəsində bu metodun tətbiqi nəticəsində 4-6 saat ərzində antibiotik həssaslıq testinin icra olunması böyük önəm daşıyır” - deyə L.Həşimova bildirib.
Şöbə müdiri digər bölmələr barədə də ətraflı məlumat verib: “Biokimyəvi bölməmiz də ən müasir avadanlıqlarla təchiz olunub. Burada əksər biokimyəvi analizlər yüksək dəqiqliklə icra edilir. Nümunə materialı olaraq qan, sidik və serebrospinal maye (CSF), drenaj maye, assit maye və s. istifadə olunur. Aparılan ümumi testlərə aşağıdakılar daxildir: qan şəkəri və HbA1c (diabetin monitorinqi üçün), böyrək funksiyası testləri, qaraciyər fermentləri, lipid profili, hormon analizi, elektrolitlər, vitamin və mineral səviyyələri və s.
Mikroskopiya bölməsində hüceyrəvi, bakterioloji və parazitoloji müayinələr aparılır. Sidiyin, nəcisin ümumi analizi, spermoqramma, genital, uretral, periferik yaxma, prostat şirəsi və digər mikroskopik müayinələr həyata keçirilir. Bu bölmə tez-tez biokimyəvi və mikrobioloji bölmələr ilə inteqrasiya halında çalışaraq xəstəliklərin diaqnostikasında mühüm rol oynayır.
Hematologiya bölməsində qanın ümumi analizi, koaqulyasiya göstəriciləri, laxtalanma faktorları, qan qrupu, Rh faktorunun təyini və digər müayinələr aparılır. Bu müayinələr müxtəlif qan xəstəliklərinin, o cümlədən anemiya, leykemiya, hemofiliya və digər hematoloji pozğunluqların diaqnostikasında və monitorinqində istifadə olunur.
İmmunologiya bölməsində immun sistemi və yoluxucu xəstəliklərlə bağlı müxtəlif laboratoriya müayinələri aparılır. Burada əsasən aşağıdakı analiz və üsullardan istifadə olunur: immunoqlobulinlər, komplement sistemi, autoantikor testləri, sitokinlər, seroloji testlər (ELISA), Hepatit B, C, HİV, sifilis, TORCH infeksiyaları, müxtəlif patogenlərin spesifik markerlərinin təyini və digər viral/bakterial infeksiyaların təyini”.
L.Həşimova analiz nəticələrində mümkün səhvlərə toxunaraq qeyd edib ki, bu səhvlər laborator analiz prosesinin müxtəlif mərhələlərində - preanalitik, analitik və postanalitik mərhələlərdə baş verə bilər. Ən çox rast gəlinən xətalar preanalitik mərhələdədir ki, bu da analiz materialları laboratoriyaya daxil olana qədər baş verir. Pasiyentin səhv hazırlanması: məsələn, qanda qlükozanın dəqiq təyini üçün pasiyentin ən azı 8 saat aclıq rejiminə riayət etməsi tələb olunur. Lakin bu qaydaya əməl edilmədikdə, nəticələr normadan yüksək alına bilər. Nümunənin səhv götürülməsi: məsələn, nümunə qan götürülən tüpün tərkibindəki antikoaqulyant maddələr bərabər qarışdırılmadıqda, laxtalanma baş verə bilər.
Analitik və postanalitik xətalar mərhələsindən də söhbət açan şöbə müdiri, rəhbərlik etdiyi laboratoriyanın həftənin yeddi günü, 24 saat fasiləsiz fəaliyyət göstərdiyini və tədris prosesinə də mühüm töhfə verdiyini qeyd edib: “Hazırda laboratoriyada kurator həkimlərə təhkim olunmuş həkim-laborant və həkim-mikrobioloq ixtisasları üzrə 15 rezident təhsil almaqdadır. Biz həmin rezidentlərin tədrisi ilə də məşğul olur, həftəlik seminarlar təşkil edirik. Qarşıdan Tələbə Elmi Cəmiyyətinin (TEC) elmi konfransı gəlir. Bu tədbirə qatılmaq üçün tezislər və prezentasiyalar hazırlamışıq".
.png.jpg)
.png.jpg)
.png.jpg)
